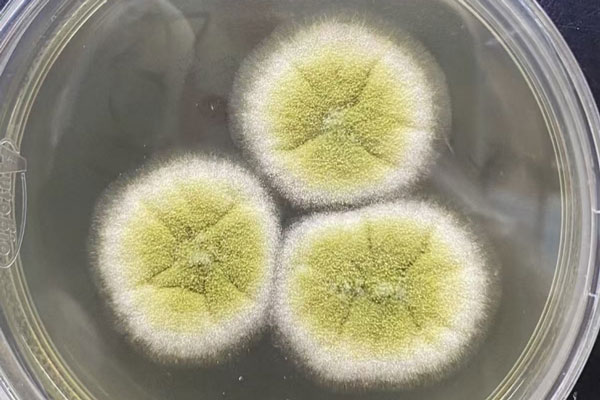
注意！這種致癌物可能正藏在家里！很多人天天接觸卻不知道！

科室導航
Departments
專家介紹
Doctors

謝雯
主任醫(yī)師
謝堯
主任醫(yī)師
邢卉春
主任醫(yī)師

張福杰
主任醫(yī)師

李興旺
主任醫(yī)師

王憲波
主任醫(yī)師

江宇泳
主任醫(yī)師

陳京龍
主任醫(yī)師

黃宇明
主任醫(yī)師

馮恩山
主任醫(yī)師

段雪飛
主任醫(yī)師

李麗
主任醫(yī)師

劉景院
主任醫(yī)師

管浩
副主任醫(yī)師

李坪
主任醫(yī)師

王宇
主任醫(yī)師

向攀
主任醫(yī)師

李新剛
主任醫(yī)師
蔣力
主任醫(yī)師

劉慶軍
主任醫(yī)師

趙昌松
主任醫(yī)師

程灝
主任醫(yī)師

姚艷青
副主任醫(yī)師
倫文輝
主任醫(yī)師

吳焱
主任醫(yī)師

孫揮宇
主任醫(yī)師

房高麗
主任醫(yī)師

賈洪誠
主任醫(yī)師

常宇飛
主任醫(yī)師

- 喜報!地壇醫(yī)院再次獲批北京市重點實驗室!2026-02-06
- 八秩芳華 地壇心聲 | 我與地壇的不解之緣2026-02-05
- 別讓“眼皮耷拉”困住視線,老人更要注意這個問題!2026-02-03
- 總腹瀉便秘腹痛,卻查不出原因?可能是腸道菌群“亂套了”!2026-02-02
- 又一項目啟動!北京地壇醫(yī)院牽頭國家科技重大專項啟動會召開2026-01-30
- 北京地壇醫(yī)院召開2025年度醫(yī)療工作會2026-01-30
- 關于尼帕病毒,北京地壇醫(yī)院醫(yī)生解析5大核心關鍵點2026-01-29
- 八秩芳華 地壇心聲 | “肝”心守護:一件白大褂的溫度傳承2026-01-29

- 北京大學地壇醫(yī)院教學醫(yī)院2026年博士研究生招生擬錄取名…2026-02-02
- 首都醫(yī)科大學附屬北京地壇醫(yī)院核醫(yī)學及醫(yī)學影像檢查服務…2026-01-26
- 北京大學地壇醫(yī)院教學醫(yī)院2026年博士研究生招生擬錄取名單公示2026-02-02
- 首都醫(yī)科大學附屬北京地壇醫(yī)院核醫(yī)學及醫(yī)學影像檢查服務項目成交公告2026-01-26
- 首都醫(yī)科大學附屬北京地壇醫(yī)院血液成分分離機采購項目成交公告 (采購編號:0701-264106140054)2026-01-22
- 首都醫(yī)科大學附屬北京地壇醫(yī)院單腔體外臨時起搏器采購項目成交公告 (采購編號:0701-264106140053)2026-01-22
- 北京大學地壇醫(yī)院教學醫(yī)院博士研究生招生復試通知2026-01-21
- 首都醫(yī)科大學附屬北京地壇醫(yī)院血液成分分離機采購項目比選信息更正公告 招標編號:0701-2641061400542026-01-16
- 首都醫(yī)科大學附屬北京地壇醫(yī)院單腔體外臨時起搏器采購項目比選信息更正公告 招標編號:0701-2641061400532026-01-16
- 醫(yī)用耗材比選公告(第二次)2026-01-14
- 首都醫(yī)科大學附屬北京地壇醫(yī)院核醫(yī)學及醫(yī)學影像檢查服務項目比選采購公告2026-01-14
- 可視化鼻腸營養(yǎng)管植入設備及體外膈肌起搏器采購項目院內比選邀請函2026-01-13
- 首都醫(yī)科大學附屬北京地壇醫(yī)院順義院區(qū)老年護理中心裝修改造工程成交結果公告2026-01-12
- 首都醫(yī)科大學附屬北京地壇醫(yī)院血液成分分離機采購項目采購邀請公告2026-01-12

- 喜報!地壇醫(yī)院再次獲批北京市重點實驗室!2026-02-06
- 臨床檢驗診斷學專業(yè)獲批北京大學醫(yī)學部博士研究生培養(yǎng)點…2026-01-19
- 喜報!地壇醫(yī)院再次獲批北京市重點實驗室!2026-02-06
- 臨床檢驗診斷學專業(yè)獲批北京大學醫(yī)學部博士研究生培養(yǎng)點和博士研究生導師資格2026-01-19
- 地壇醫(yī)院楊志云、王雅杰獲評首都醫(yī)科大學2025年度校級優(yōu)秀研究生指導教師2026-01-19
- 國家傳染病醫(yī)學中心多中心醫(yī)療數(shù)據(jù)集重磅發(fā)布2026-01-07
- 地壇醫(yī)院牽頭項目獲批兩項新發(fā)突發(fā)與重大傳染病防控國家科技重大專項2026-01-04
- 聚力發(fā)展!地壇醫(yī)院協(xié)辦首屆中國公立醫(yī)院醫(yī)療美容科室建設研討會2025-12-29

- 八秩芳華 地壇心聲 | 我與地壇的不解之緣2026-02-05
- 當節(jié)育器“走失”嵌頓 我們治愈疾病,也全力守護心情2026-02-03
- 八秩芳華 地壇心聲 | 我與地壇的不解之緣2026-02-05
- 當節(jié)育器“走失”嵌頓 我們治愈疾病,也全力守護心情2026-02-03
- 八秩芳華 地壇心聲 | “肝”心守護:一件白大褂的溫度傳承2026-01-29
- 八秩芳華 地壇心聲 | 信任的重量:急診室里的生死十分鐘2026-01-22
- 新手媽媽遇顱底重疾,地壇一站式手術托舉生命與希望2026-01-21

京公網安備 11010502052111號
京公網安備 11010502052111號





